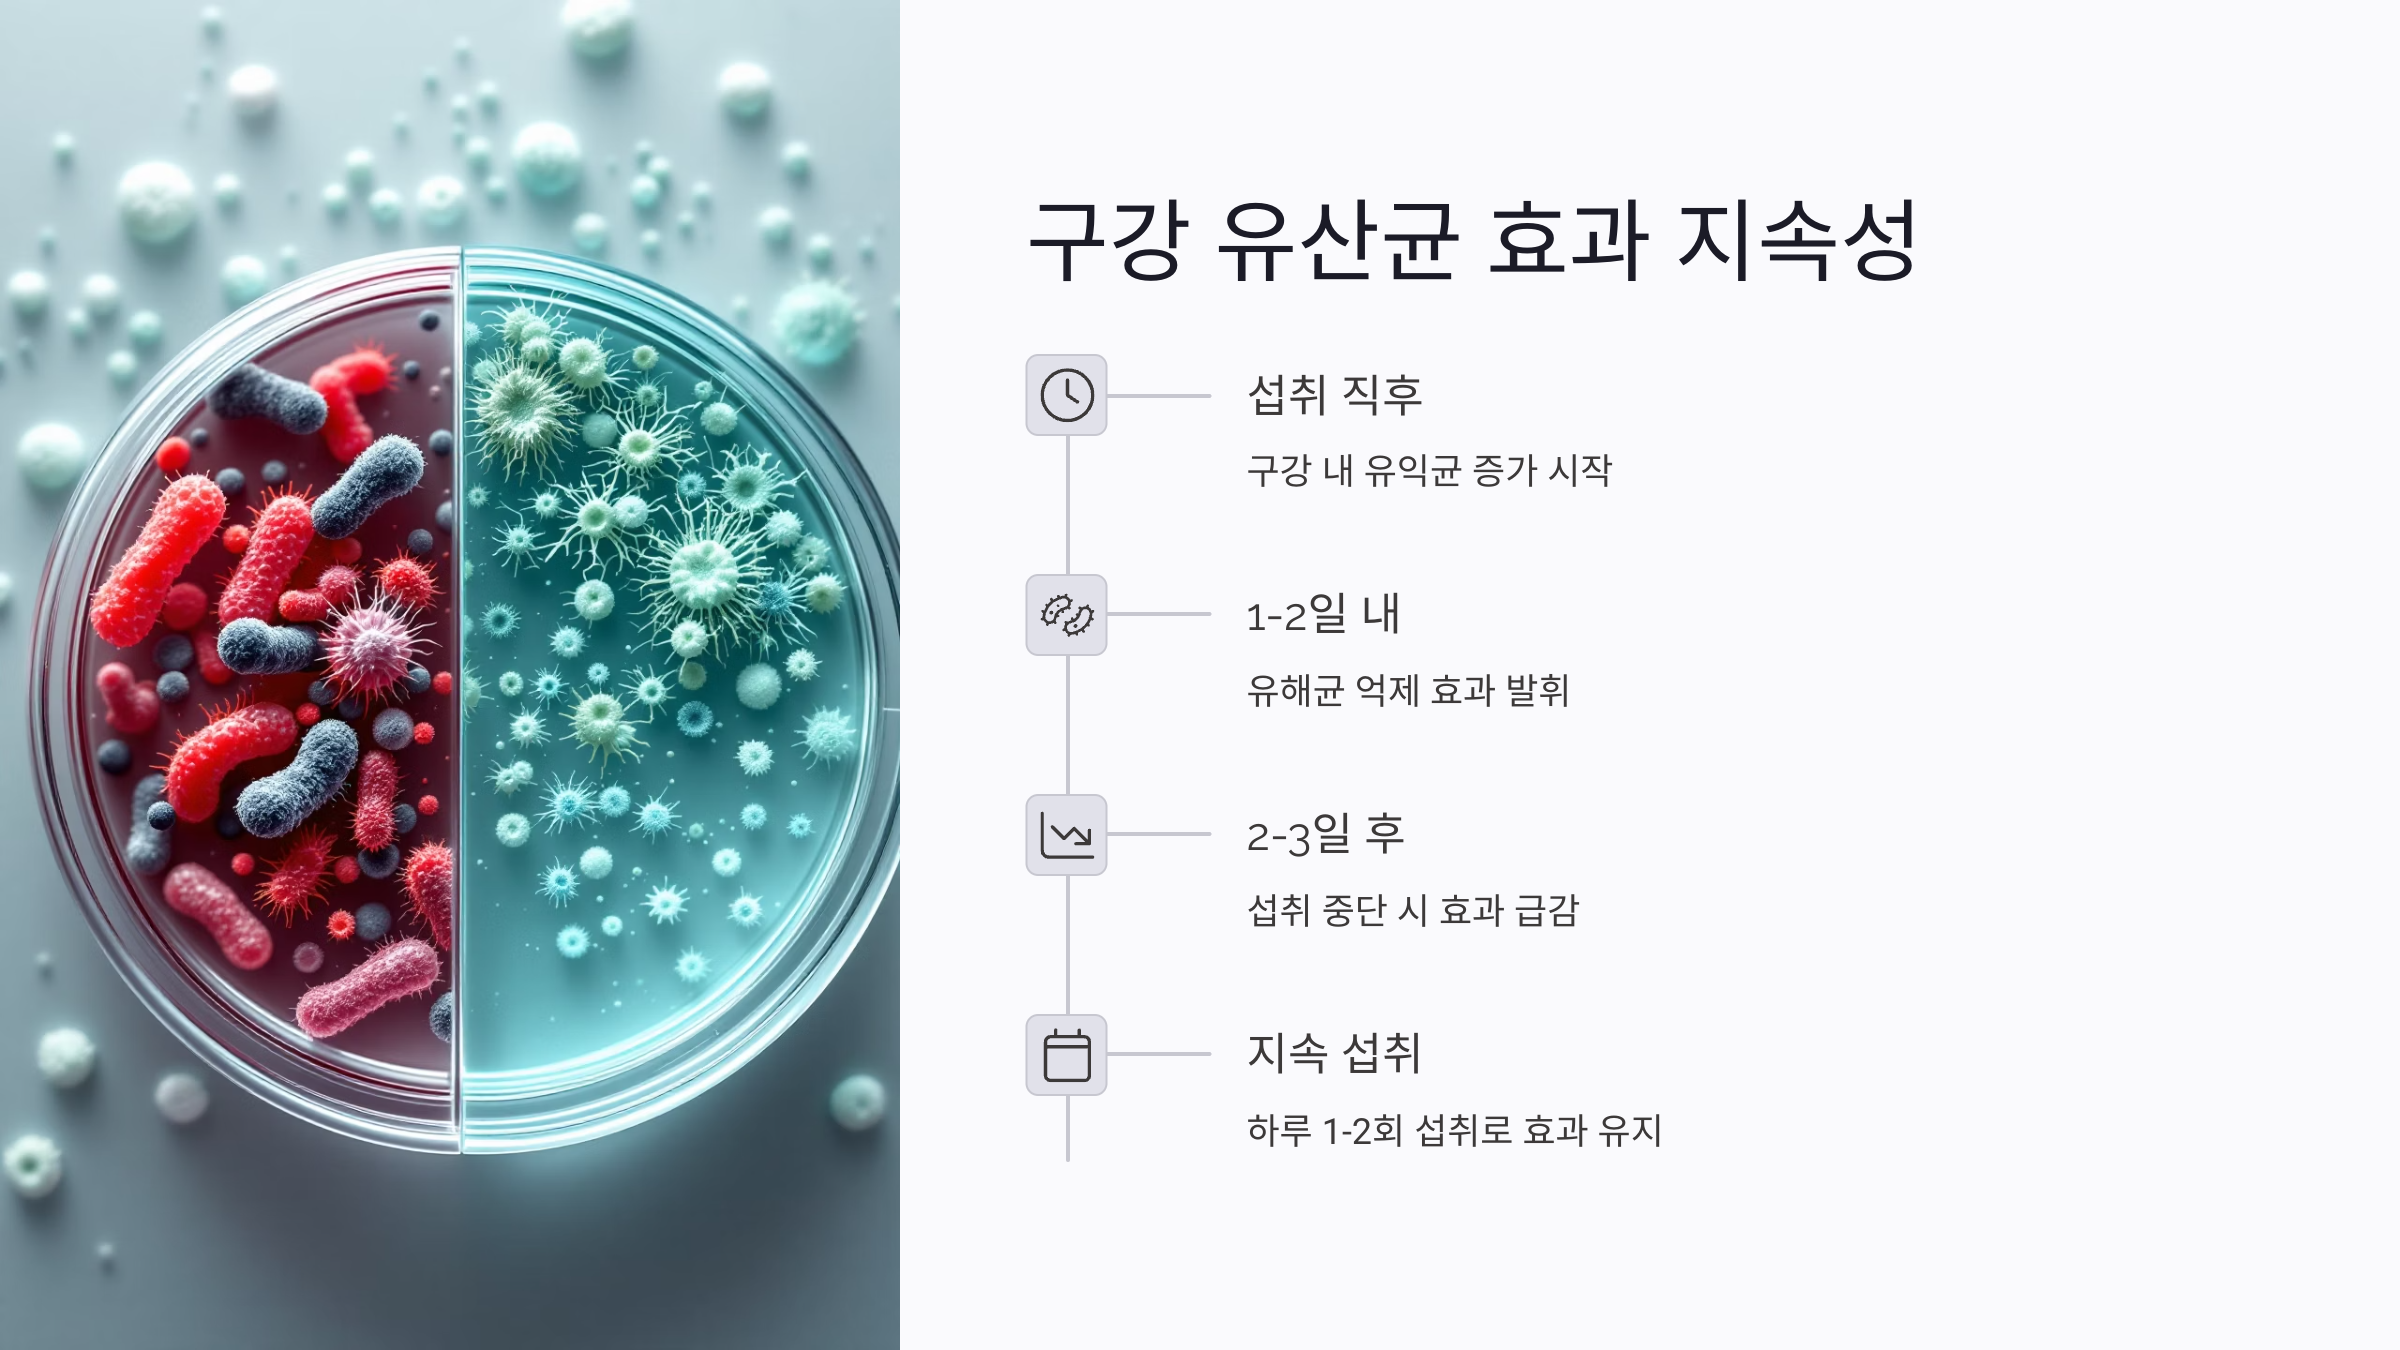
구강 유산균의 효과는 얼마나 지속될까?

구강 유산균 효과 없을까? 입냄새·충치 예방에 필요한 이유 총정리
입냄새가 고민이거나 충치 걱정이 많다면, 구강 유산균이 정말 효과 있는지 궁금하셨을 겁니다. 이 글에서는 구강 유산균을 먹지 않았을 때 발생할 수 있는 문제점부터, 입냄새 원인 세균의 정체, 임산부나 어린이의 섭취 가능 여부까지 폭넓게 다루며 구체적인 정보를 제공합니다.
또한 구강 유산균이 실제로 어떤 방식으로 구강 건강에 도움을 주는지, 치과 치료 전후에 왜 유산균이 필요하며, 제품을 고를 때 어떤 기준이 중요한지도 자세히 설명합니다.
건강한 구강 환경을 만들고 싶다면 지금부터 꼭 읽어야 할 핵심 정보가 가득합니다.
✅구강 유산균을 먹지 않으면 생기는 변화
2025년 구강 유산균으로 잇몸염증 잡는 법: 제품별 비교와 꿀팁 총정리
구강 유산균으로 잇몸염증을 완화하고 건강한 잇몸을 되찾고 싶으신가요? 오늘은 구강 유산균의 항균 작용, 제품별 특징과 올바른 사용법까지 모두 담았습니다. 전문가의 팁과 비교표도 함께
fivesh.com
⚠️입속 세균 밸런스 붕괴로 충치와 구취 증가
구강 유산균이 부족하면 유해균이 빠르게 증식하게 됩니다. 특히 스트렙토코커스 뮤탄스균이나 솔로박테리움 같은 충치균이 활발해지면서 치아 표면을 부식시켜 충치를 유발합니다.
이 과정에서 입속이 산성화되며 유익균이 줄어들고, 충치와 잇몸 질환의 위험이 크게 증가합니다.
😮입냄새를 유발하는 황 화합물 증가
입냄새의 가장 큰 원인은 혐기성 세균이 단백질을 분해하면서 만들어내는 황 화합물입니다.
특히 퓨소박테리움, 프레보텔라, 포르피로모나스 진지발리스 등의 세균은 혀 뒤쪽, 잇몸 사이에 숨어 강한 구취를 유발합니다. 유산균을 섭취하지 않으면 이들 세균의 번식이 억제되지 않아 입냄새가 지속될 수밖에 없습니다.
🦷잇몸 출혈과 치은염 가능성 증가
구강 유산균은 항염 효과가 뛰어나 잇몸 염증을 억제해줍니다. 섭취하지 않으면 치은염, 치주염으로 이어지는 잇몸 출혈과 부종, 통증이 심해질 수 있습니다.
일상적인 양치질이나 치실 사용만으로는 유해균 증식을 막기 어렵기 때문에, 유산균의 보조적인 역할이 매우 중요합니다.
🧫입냄새 유발 세균의 정체와 억제 방법
흡연으로 인한 입 냄새와 잇몸 문제, 구강 유산균으로 해결하는 5가지 방법
흡연으로 인해 입 냄새가 심해지고 잇몸 건강까지 위협받는 사실, 알고 계셨나요? 흡연자라면 반드시 알아야 할 구강 유산균의 강력한 효과와 흡연 직후 관리 팁을 담았습니다. 흡연자 입 냄새
fivesh.com
🔬혐기성 세균이 입냄새의 주범
구강 내에서 산소가 적은 환경을 좋아하는 세균들이 혐기성 세균입니다. 이들은 주로 혀 뒷면 깊숙한 곳이나 잇몸 포켓, 치주 질환 부위에 서식하며, 음식물 단백질을 분해해 황 화합물을 생성합니다.
이 물질은 계란 썩는 냄새와 비슷한 메틸메르캅탄이나 황화수소 등으로 구성되어 강한 악취를 유발합니다.
🧪구강 유산균이 세균을 어떻게 억제하는가
락토바실러스 살리바리우스 계열의 유산균은 유해균이 서식하기 어려운 환경을 만들어 냅니다.
산소 농도를 변화시키고, 유해균의 먹이를 차단하며, 혀와 잇몸 표면에 착상해 공간을 점유함으로써 이들의 번식을 막습니다. 이 과정은 입냄새를 유발하는 물질 생성을 자연스럽게 감소시키는 데 기여합니다.
👶임산부와 어린이도 구강 유산균을 섭취해도 될까?
✅임산부 복용 안전성과 주의사항
대부분의 구강 유산균 제품은 식약처에서 GRAS(Generally Recognized As Safe) 등급으로 인정받은 균주를 사용합니다. 특히 락토바실러스 살리바리우스 K12나 M18은 태아와 산모에게 독성이나 부작용이 없다는 보고가 있으며, 임신 중 구강 내 염증을 줄이는 데 도움을 줄 수 있습니다.
다만 임신 중 특별한 질환이나 약물 복용 중이라면 반드시 전문의와 상담 후 섭취하는 것이 안전합니다.
🧒어린이 섭취 시 고려할 점
3세 이상의 어린이는 대부분 섭취가 가능하며, 입 안에서 천천히 녹이는 제형이 좋습니다.
어린이용으로는 감미료가 포함되지 않은 무설탕 제품이나 알레르기 유발 성분이 없는 제품을 선택해야 합니다. 유산균은 조기에 섭취할수록 충치균의 정착을 막는 데 유리하므로, 구강 건강 교육과 함께 도입하는 것이 좋습니다.
⏳구강 유산균의 효과는 얼마나 지속될까?
🕒정착 효과는 2~3일, 꾸준한 섭취가 중요
유산균은 입속에 영구적으로 정착하기 어렵기 때문에, 섭취를 중단하면 2~3일 이내에 유익균 비율이 급격히 감소합니다.
하루 1~2회 이상 섭취해야 효과가 지속되며, 특히 취침 전이나 아침 양치 후 공복 상태에서 섭취할 경우 흡수율과 정착률이 높아집니다.
💡정착을 높이는 습관도 중요
혀클리너 사용, 충분한 수분 섭취, 입안 청결 유지 등의 생활습관은 유산균의 생존률을 높여줍니다.
특히 자극적인 음식이나 잦은 커피·알코올 섭취는 유익균을 죽일 수 있으므로 주의가 필요합니다.
🦷치과 치료 전후에 구강 유산균이 중요한 이유
💉치과 시술 전 세균 감염 예방
발치, 스케일링, 임플란트 등 치과 시술을 앞두고 구강 유산균을 섭취하면 입속 세균 밸런스를 안정화시켜 감염 가능성을 줄일 수 있습니다.
염증성 반응을 억제하고, 잇몸 출혈이나 통증 완화에도 도움을 주기 때문에 회복 기간이 짧아질 수 있습니다.
💊항생제 복용 후 유익균 복구에 효과적
치과 치료 후 항생제를 복용하면 구강 내 유익균도 함께 사라지게 됩니다. 이때 유산균을 빠르게 보충하지 않으면 병원성 세균이 먼저 자리를 차지할 수 있습니다.
구강 유산균은 손상된 미생물 환경을 정상화시켜, 구강 건강 회복을 빠르게 돕습니다.
📊구강 유산균 필요성과 효과 요약
| 항목 | 설명 | 주의사항 |
|---|---|---|
| 섭취 필요성 | 입속 유해균 억제, 입냄새 완화, 충치·잇몸질환 예방 | 꾸준한 섭취 필수 |
| 입냄새 유발 세균 | 퓨소박테리움, 포르피로모나스 진지발리스 등 혐기성균 | 혀·잇몸·치아 사이에서 서식 |
| 임산부 섭취 가능 여부 | GRAS 등급 안전 균주 사용 | 의사 상담 후 섭취 권장 |
| 어린이 섭취 가능 여부 | 어린이 전용 제품 다수 출시 | 목 넘김 어려운 어린이는 주의 필요 |
| 효과 지속 시간 | 평균 2~3일, 일시적 정착 | 하루 1~2회 지속 섭취로 효과 유지 |
| 치과 치료와의 연관성 | 감염 예방 및 회복 촉진 | 항생제 복용 후 유산균 보충 필수 |
🔍구강 유산균과 일반 유산균의 차이점
🧬정착 부위와 목적이 전혀 다름
일반 유산균은 장 건강 개선을 목적으로 소장에서 작용하지만, 구강 유산균은 입속 점막이나 혀, 잇몸에 직접 작용합니다.
락토바실러스 살리바리우스 K12, M18은 타액과 혀 표면에서 증식하며, 충치균 억제와 입냄새 완화에 특화된 균주입니다.
🛒유산균 제품 선택 시 확인해야 할 기준
📦성분표와 CFU 수치 확인
하루 섭취량당 보장균수(CFU)가 10억 이상이며, K12 또는 M18 같은 구강 특화 균주가 명시되어 있는 제품을 선택해야 합니다.
정제 형태보다 씹어서 녹이거나 혀에 붙이는 제품이 구강 내 정착률이 높습니다.
🔒안정성과 보관 방식도 중요
냉장보관이 필요한지 여부, 유통기한 내 균주의 생존율 보장 여부를 반드시 확인해야 합니다.
무설탕, 무색소, 무방부제 제품이 좋으며, 어린이나 임산부의 경우 알레르기 유발 물질 유무도 체크해야 합니다.
🌐전 세계 연구에서 입증된 구강 유산균의 효과
구강 유산균의 효능은 세계적으로 다양한 연구에서 입증되고 있습니다. 일본 나고야 대학의 연구에서는 K12 유산균을 1개월 섭취한 아동의 입냄새 수치가 평균 47% 감소했고, 뉴질랜드의 임상 실험에서는 치은염 개선 효과가 2주 이내에 나타났다는 결과도 있습니다.
이처럼 구강 유산균은 과학적으로도 입증된 효과를 갖고 있으며, 장기적인 구강 건강에 있어 신뢰할 수 있는 선택지입니다.
입속 건강은 삶의 질과 직결됩니다. 유산균은 단순히 보조적인 수단이 아니라 입속 미생물 환경을 바꾸는 핵심 도구입니다.
하루 한 번의 작은 습관이 평생의 건강을 결정짓는다면, 오늘부터 실천해보는 것이 어떨까요?
댓글